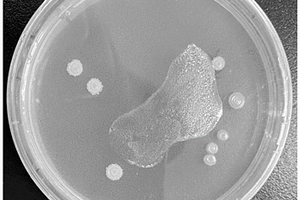

全部

 1031
1031
 0
0
本发明公开了一种智能化废物处理装置,包括:箱体、内箱体、一组压缩装置、自动封袋装置和顶升装置,所述内箱体设于箱体的内部,所述压缩装置设于内箱体和箱体之间,且所述内箱体的两侧相对设有压缩装置,所述自动封袋装置设于内箱体的上方,所述顶升装置设于内箱体的下方,所述内箱体的开口处套有垃圾袋,所述压缩装置、自动封袋装置和顶升装置均与控制装置连接。本发明中所述的一种智能化废物处理装置,通过压缩装置对垃圾箱内的垃圾袋进行压缩,并通过自动封袋装置对压缩后的垃圾袋进行封袋处理,不仅减小了垃圾的体积,同时还对垃圾袋进行了封口处理,自动化程度高,给垃圾处理带来了诸多的便捷,减少垃圾对人们身体造成的危害。

 940
940
 0
0
本发明公开了一种群仓构建固废填埋场的方法和装置,是属于固体废弃物处理工程技术领域。现有垃圾填埋场产生的大量渗沥液一直是难以攻克的技术难题,本发明可有效阻断地表径流水和雨水入侵,使垃圾填埋场无外溢渗沥液产生,从而解决了这一技术难题。现有尾矿库如遇长时间降雨,库中尾矿呈液态对尾矿坝产生很大侧压力,一旦垮坝将形成人造泥石流对下游造成巨大危害。本发明除有效阻断地表径流水和雨水入侵外,还可长期持续排出尾矿中积水使其呈固态,最终形成尾矿干化填埋场彻底消除垮坝隐患。特别具有重要意义的是:本发明适用于在已建垃圾填埋场(或尾矿库)进行拓建和覆盖,不仅可以消除老坝体安全隐患,还可以利用现有场地增加很大库容。

 1008
1008
 0
0
本发明系统公开了基于富含有价元素固废协同处置的高炉冶炼系统,属于冶金装备及节能环保领域。方案包括高炉及其加料系统,从上往下,所述高炉依次分为炉喉、炉身、炉腰、炉腹、炉缸5部分,炉缸上部沿炉缸周向均匀设置若干风口,所述加料系统位于高炉顶部中心区域,包含受料斗、料罐、料流阀、气密箱、旋转布料溜槽,在所述高炉炉腰上沿、炉身下部沿炉身周向均匀设置至少一层气体引出口,所述气体引出口总数量不少于高炉风口数量的三分之一。本发明系统结构紧凑、占地面积小、密封性和稳定性好、投资和运行成本低,彻底解决了高炉冶炼时有价元素循环富集的危害,拓展了高炉消纳社会固废功能,高效回收了随炉料带入的有价元素,提高了铁水质量。

 1079
1079
 0
0
本实用新型公开了一种钻床的废屑回收装置,所述钻床设于机床底座上,所述废屑回收装置包括设于机床底座下表面上的漏斗收集装置和设于机床底座边缘上的金属吸附装置,所述机床底座其中一角开设一孔,所述漏斗收集装置固装于孔的正下方,所述金属吸附装置与孔的边缘相邻设置。本实用新型结构设计简单、合理,可以轻松实现各种金属废屑的分离,减少了金属粉末对工人的身体危害,节省了清扫和分类时间,提高了生产率。

 1074
1074
 0
0
本实用新型公开了一种电镀废水处理用蒸馏装置,包括蒸馏釜本体,所述蒸馏釜本体的一侧嵌合连接有进水管,且蒸馏釜本体的底端一侧开设有排污槽,所述蒸馏釜本体的内部安装有加热管,其蒸馏釜本体的内壁底端安装有清理机构,且蒸馏釜本体的表面连接有压力表,所述蒸馏釜本体的顶端固定有蒸汽管。本实用新型中,在泄压机构的作用下,当加热管在蒸馏釜本体加热废水时,蒸馏釜本体内因高温会导致气压增大,其蒸馏釜本体内的气压温度超过一定时,会挤压着托板向蒸馏釜本体内壁移动,通过托板带动着密封塞向上移动,可以自动的对其蒸馏釜本体进行泄压,防止蒸馏釜本体内压力过大,造成炸罐的危险,提高了废水蒸馏加工的安全性。

 1127
1127
 0
0
本实用新型涉及一种喷漆线用废气处理机构,包括工作台,所述工作台上方设有防护罩,所述防护罩内等距间隔排列设有若干喷漆设备,且所述喷漆设备设置于所述工作台上,所述防护罩的顶部一侧设有第一风箱,所述第一风箱顶部及底部均设有通风滤网,所述第一风箱内腔设有抽风机,所述防护罩顶部靠近所述第一风箱的一侧设有三通管道,所述三通管道的底部设有导气斗,所述三通管道远离所述导气斗的一端设有导气管,所述防护罩顶部远离所述三通管道一侧设有处理箱,所述处理箱内腔设有光触媒多孔层,本实用新型能够对加工过程中产生的废气进行吸收并对废气进行净化过滤处理,减少了对工作环境及工作人员的危害和影响。

 944
944
 0
0
本发明提供了一种应用于废气处理风管系统的高气密性管件,包括风管以及用于连接风管的接头,其特征在于:风管包括外管层和内管层,所述外管层和内管层间设有中空层,外管层和内管层间设有若干连接筋,接头包括内接层和外接层,内接层和外接层间设有若干连接肋,所述连接肋与内接层和外接层间形成中空通道,内接层和外接层的两端头分别对称设有第一内螺纹和第二外螺纹,风管内管层端头设有与第一内螺纹配合的第一外螺纹,风管外管层端头设有与第二外螺纹配合的第二内螺纹;本发明基于风管和接头的中空层结构配合设计,实现了管件的高气密性效果,降低有毒有害气体泄露,对大气和工人的污染危害,降噪效果提高废气处理工作环境舒适度。

 1170
1170
 0
0
本实用新型公开了一种废气处理用立式化学喷淋塔,涉及废气处理技术领域,包括箱体,箱体的下表面固定连接有支脚,箱体的内侧下表面右侧固定连接有水滤箱,水滤箱的右侧固定连接有进气管,进气管的一侧固定连接有多个分气管,多个分气管的另一端均固定连接有散气头,水滤箱内部装有滤液,水滤箱的左侧固定连接有第一气管,第一气管的另一端固定连接有第一喷淋箱。该废气处理用立式化学喷淋塔,通过四个分气管可以使气体分成四路同时由散气头对其进行打散,加快了工作效率,通过将气体打散后可以使其内部的颗粒、杂质等被滤液滤除,实现第一步的物理过滤,通过后续的工序使其不在具有危害性,具有结构简单操作方便的优点。

 1040
1040
 0
0
本发明揭示了一种废金属包装容器智能无害化处理及资源化循环利用工艺,包括如下步骤:1)上料;2)撕碎;3)一级清洗;4)团粒;5)分选;6)二级清洗;7)脱水;8)废气处理;9)废水循环处理;10)系统控制。本发明将各类危险包装容器进行集中破碎、清洗、回收利用,采用先进的破碎技术,在常温状态下对物料进行有效切割,达到物料减容效果,处理后的物料大小可控,采用物理和化学分离法,将金属从其他物料中分离,提高回收利用率。

 780
780
 0
0
本实用新型公开了一种酸性废气处理装置,包括风机和氧化炉;还包括:前置洗涤装置、后置洗涤装置、冷却塔、换热器和骤冷装置;风机、前置洗涤装置、氧化炉、骤冷装置和后置洗涤装置通过管路依次串接形成酸性废气的处理路径;冷却塔提供冷源并通过换热器将骤冷装置中的水冷却。本实用新型具有的有益效果:能够将酸性废气进行中和和裂解转变为无危害的洁净气体。

 997
997
 0
0
本实用新型涉及一种固废处理系统用污水处理装置,应用在污水处理技术领域,解决了浪费资源的问题,包括破乳装置,破乳装置包括依次连接的收集池、气浮池、中间水池和初沉池,收集池与气浮池之间设置有将收集池内的废水抽至到气浮池内的第一提升泵,气浮池的一侧设置有加药箱,加药箱上设置有第一管道,第一管道的一端设置有用于将加药向内的药水喷洒在气浮池内的药用喷头,生化装置包括依次连接的水解酸化池、接触氧化池、反应池、二沉池、消毒池和回用水池,水解酸化池与初沉池之间通过第二管道连通,储泥装置包括依次连接的淤泥池和板框压滤机;具有对危废水进行处理产生回用水,减少自来水的使用,节约成本,提高资源的利用率的效果。

 957
957
 0
0
本实用新型属于废气处理技术领域,尤其为一种纺织后整理设备的废气净化装置,包括处理箱,所述处理箱内开设有蓄水腔和净化腔,所述处理箱的内壁上固定安装有隔板,所述隔板上开设有通风口,所述处理箱的顶部固定安装有抽风机,所述抽风机的出风口固定安装有通风管的一端,所述通风管的另一端延伸至蓄水腔内,所述通风管上固定安装有多个出气嘴,所述处理箱的底部固定安装有与蓄水腔相连通的排污管,所述处理箱的内壁上固定安装有位于净化腔内的除雾器。本实用新型设计合理,通过清水、除雾器和滤板便能对废气进行最大程度的净化,有效提高了周围环境的空气质量,减少了对人们的身体危害,提高了生存质量。

 903
903
 0
0
一种造纸废弃物处置系统,包括:预处理系统、无氧裂解系统、裂解产物收集系统及配套能源气体管理系统;预处理系统由进料装置,预烘干装置,粉碎造粒装置,输送装置,依次连接组成。无氧裂解系统包括裂解炉和无氧保障装置;裂解炉为流化床裂解模式,裂解温度为400‑800℃,加热方式为间接加热。裂解产物收集系统由布袋式固体产物收集装置和气体产物过滤装置组成。配套能源气体管理系统包括储气缓冲装置、燃气锅炉装置及换热器装置。本发明优点,可以处理造纸工业中产生的废弃物,大大减轻了生态环境的破坏,同时使用本系统时,无需对废弃物进行分拣,处理过程中无难处理高危二次污染物产生,处理后的产物可以被再利用。

 1231
1231
 0
0
一种含有聚乙烯苯磺酸的制革废水处理剂,处理剂由以下成分按照重量比组成:聚乙烯苯磺酸为9~16份、长石粉为6~7份、碳酸钙为4~8份、半纤维素为7~12份、明胶为8~18份、水146~166份。制备得到的处理剂可用于降低制革废水中的硫化物总量和BOD5值,降低制革废水的排放危害。

 874
874
 0
0
本实用新型公开了一种用于采样检测的废气处理装置,包括风机、环形通气管、密封反应池,所述风机的出风口连接所述环形通气管,所述环形通气管远离风机的一侧通过排气管道贯通连接所述密封反应池,所述风机的进风口连接有进气管道,所述风机通过支架安装于平台上,所述环形通风管与风机连接处通有采样管,所述采样管上设有六通阀进样器,所述六通阀进样器连接有检测仪,所述排气管道上沿气体流动方向依次设有压力传感器和电气阀。该装置通过设有环形通气管和密封反应池,能够在样品气体进行采样检测后,对排出的废气进行及时有效的处理,有利于实验环境的维持,减少室内相关组分对检测样品结果的干扰,并且避免了废气对人体的危害。

 1024
1024
 0
0
本发明一种废旧锂电池处理专用设备,包括、粉碎齿轮、传送带、上料中转仓、裂解炉体、裂解气缓冲罐和固体产品仓;所述与粉碎齿轮连通,所述粉碎齿轮的出料口通过传送带将物料运送至上料中转仓,所述上料中转仓通过舱门与裂解炉体连接,所述裂解气缓冲罐通过预留排气管和预留进气管与所述裂解炉体连接,所述固体产品仓通过固体出料舱门与所述裂解炉体连接。废旧锂电池在裂解炉体内部发生无氧裂解反应,生成固体无机残留物以及裂解气,设备操作简单,可实现连续化生产,处理效率高;无需对废旧锂电池进行分拣分类,适用范围广;且产物可回收,环境危害小。

 1229
1229
 0
0
本实用新型涉及一种废油墨收集装置,其设置在电线印刷工作平台的底端,其包括一收集盒,收集盒为漏斗形结构,收集盒大截面面积的一端连接电线印刷工作平台,收集盒小截面面积的一端连接有导流管,导流管将由电线印刷工作平台上流入收集盒中的废油墨导流至油墨收集箱,导流管将收集盒的出口端与油墨收集箱的进口端连接。该装置收集了喷印装置的废油墨,使电线外表干净清爽;并且防止油墨的飞溅,保护了设备的外观。废油墨收集盒底部为稀释剂,与油墨发生化学反应,杜绝了油墨漂浮在顶上,降低了对人体的危害程度。

 1064
1064
 0
0
本实用新型公开了一种医疗废水采集装置,包括承载板,承载板的上方设有横板,横板底端的一侧固定连接有采集筒,采集筒的内腔滑动连接有橡胶活塞,橡胶活塞的顶端设有拉杆,采集筒一侧穿插连接有出料筒,采集筒和出料筒的内腔分别设有第一密封塞和第二密封塞,第一密封塞底端的两侧和第二密封塞一侧均设有T型杆,T型杆的挖补套接有弹性弹簧。本实用新型通过设有的采集筒、橡胶活塞和拉杆能够利用压强差自动将废水吸入采集筒中,降低劳动强度,再配合出料筒、第一密封塞、第二密封塞、T型杆和弹性弹簧的使用能够进行一次性取液,进一步降低技术人员二次取液检测的劳动强度,同时避免废水与人体接触危害健康。

 1007
1007
 0
0
本发明涉及一种含染料废水处理方法,特别涉及一种采用生物技术对含染料废水中染料的去除及染料分子脱色降解的处理方法,属于环境保护技术领域。其具体方法是:将真菌Penicillium sp.P-1投入到染料水中,吸附2~5h后,把吸附有染料分子的真菌放回培养液中,再投加细菌Aeromonas sp.M10等,对吸附在菌丝上的染料分子进行脱色降解处理。2类特殊的微生物通过协同代谢、共代谢等作用能快速将多种染料或其它有机毒物分子脱色降解,因此,可大大降低有害物质的处理成本,避免了属于难降解有机物的染料分子进入天然水体而在环境中积累的危险,具有明显的经济效益、环境效益和社会效益。

 1118
1118
 0
0
本申请涉及一种熔炉废渣回收装置,其包括承接平台,所述承接平台上,所述承接平台位于熔炉排废口的下方,所述承接平台上设有运输机构,所述运输机构包括若干运送板,所述运送板之间设有连接轴,若干个所述运送板依次形成运送带且运送带首尾相接,所述承接平台底部开设有供运送带穿过的容纳腔,所述连接板上设有驱动齿条,所述承接平台上设有若干驱动电机,所述驱动电机的电机轴上固设有与驱动齿条啮合的驱动齿轮。本申请具有通过设置承接平台和运送板,当废渣从熔炉中排出后落在运送板上,通过运送板将废渣从熔炉下方运出,再通过承接装置对废渣进行承接和转运,使工作人员无需行至熔炉正下方,减少了发生危险的可能性的效果。

 1001
1001
 0
0
本发明公开了一种具有废气净化功能的激光焊接机,包括控制箱、操作箱、净化箱和储水箱,所述控制箱的一侧外壁安装有操作箱;所述操作箱的顶部安装有上下布置的网板,上方所述网板的顶部中心安装有转台,所述转台的顶部安装有置物台,下方所述网板的底部安装有风机,所述操作箱的一侧外壁安装有净化箱,所述操作箱的一侧外壁安装有输送管,所述输送管的内部安装有净化筒,所述净化箱的内部安装有多层过滤板。本发明通过在焊接时启动风机将焊接过程产生的废气吸进净化箱内,在输送过程中经由净化筒初步净化后再由过滤板对废气进行二次过滤,最后再经由排气管排放出去,在一定程度上避免了废气未被过滤直接排放而危害人体健康的情况发生。

 1009
1009
 0
0
本实用新型涉及废纸处理设备技术领域,公开了一种废纸处理用的除尘装置,为解决现有技术中的废纸处理设备没有除尘效果的问题,所述支架的下端设置有底座,且支架的上端位置处滑动连接有压制板,所述支架的顶端设置有与压制板连接的液压杆,所述压制板的两侧均设置有连接架,所述连接架的一端均固定设置有吸尘箱,所述吸尘箱的四个外侧面均设置有警示带。本实用新型在设备的压制板两侧设置有吸尘箱,能够在压缩废纸体积的同时对飘散的灰尘进行吸附,将灰尘吸附进箱体内部的水箱中进行沉淀,保证了工作区域的卫生,降低了清洁难度,避免飘散的灰尘吸入操作人员的呼吸道导致危害健康的问题,保证了操作人员的健康。

 799
799
 0
0
本实用新型提供一种工业废弃物处理的烟尘净化处理系统,烟尘依次通过吸收塔、布袋除尘器和水循环洗涤塔最终环保排放,吸收塔对烟尘进行初级中和脱酸和除尘处理,同时,通过对吸收塔内温度环境的控制能够有效遏制二噁英的再次合成;初级处理后的烟尘进入布袋除尘前通过向管道内喷洒石灰粉,进行二次中和脱酸和吸附水,随后在布袋除尘器袋壁上沉积,形成粉网;同时喷洒活性炭分,进行吸附重金属及去除废气中的PCDDS/PCDFS成分,同样在随后的布袋除尘器袋壁上沉积,形成粉网;布袋除尘器对废气进行二次彻底除尘,最终在水循环洗涤塔内捕集活性炭及飞灰、除酸,将二噁英控制在0.5ngTEQ/Nm3以下,最终从烟囱中符合国标GB18484-2001(《危险废物焚烧污染控制标准》)的标准环保排放。
1079
1079
 0
0
一种丙烯酸树脂乳液废水降解菌种、培养方法及应用,所述丙烯酸树脂乳液废水降解菌种为嗜麦芽寡养单胞菌(Stenotrophomonas maltophilia),已于2020年8月24日保藏于中国微生物菌种保藏管理委员会普通微生物中心(CGMCC),保藏编号为CGMCC No.20539。本发明方法与物理化学处理法相比可以在低能耗,温和的条件高效的处理丙烯酸树脂乳液废水,且无废气、危废等有害物质排放。

 1078
1078
 0
0
本申请涉及危废仓储技术领域,尤其是涉及一种核废料的仓储仓库,其包括仓库本体,所述仓库本体的内顶面设有滑轨,所述滑轨上设有能够沿所述滑轨方向移动的滑座,所述滑座上设有滚珠丝杆机构,所述滚珠丝杆机构通过第一电动推杆连有用于夹持核废料容器的夹持机构;所述仓库本体的内底面上设有若干个轨道组,每个所述轨道组均包括两条相互平行且并列设置的分轨道,每个轨道组上均设有仓储货架,所述仓储货架能够在对应的所述轨道组上滑动,若干个所述仓储货架叠放设置。本申请能够改善核废料的仓储仓库的空间利用率较低的问题。

 969
969
 0
0
本发明公开了一种过滤效果好的废气处理设备,包括壳体,所述壳体的顶部固定连接有第一真空泵,所述第一真空泵的出气端贯穿至壳体的内腔并连通有出气罩,所述第一真空泵的进气端连通有进气管,所述壳体内腔两侧的顶部横向固定连接有第一过滤网。本发明通过设置第一真空泵、第一过滤网、活性炭过滤网、导流罩、碱性溶液箱、第一导流管、酸性溶液箱、消毒箱、喷淋箱、第二真空泵、水泵和喷淋管的配合使用,解决了现有的废气处理设备在使用过程中通常对废气过滤处理的结构较为单一,使得废气可以会有有害气体和细菌等残留,导致无法到达理想的过滤的效果,可能会对环境造成二次危害的问题。

 825
825
 0
0
本实用新型公开了一种自动排废模切机,包括底座、排气口和支架,所述底座的上端连接有控制台,所述排气口位于废料收集箱的外表面,所述抽风机的正上方设置有废料槽,所述弹簧上端连接有下模座,且下模座的上方设置有传送带,所述传送带的两端与转动轮相连接,所述支撑杆位于控制台的左右两侧,所述支架固定在废料收集箱的上方,且支架的下方安装有升降装置,所述升降装置的下端连接有模切刀组件,且模切刀组件位于下模座的正上方。该自动排废模切机,避免了模切机在模切时产生的废料需要人工处理,内部模切刀组的高速运动使得废料清理更加危险,需要暂停机器然后再清理,使得模切机工作效率变慢,长时间不清理会导致模切机堵塞的问题。

 1082
1082
 0
0
本实用新型公开了一种密封型废气回收装置,涉及机械设备自动化技术领域,旨在解决布料切割时产生的废气难以进行密封收集,其技术方案要点是:包括密封箱,密封箱上转动连接有送料辊,密封箱上开设有进口,进口内设置有密封牵引装置,密封箱的底面包括板体一和板体二,板体一和板体二之间存在间隙,间隙内设置有密封夹紧装置,密封夹紧装置位于密封牵引装置下方,密封箱的内部一侧设置有割料机,割料机位于密封牵引装置与密封夹紧装置之间,密封箱的内部设置有贯通密封箱的吸气管,吸气管位于密封箱外的一端固定连接有抽风机,抽风机固定连接在密封箱上。本实用新型能够对废气进行密封收集,以防对人体产生危害。

 1267
1267
 0
0
本实用新型揭露一种废酸处理用干燥塔,包括塔体,所述塔体底部固定安装有底座,且塔体顶部固定连接有通气口,所述塔体外部连接有进水口,且塔体内部安装有雾化机构,所述雾化机构包括有蓄水槽,蓄水槽内部安装有活塞,所述活塞底部固定连接有弹簧,活塞底部固定安装有第一接杆,所述第一接杆底部连接有按压开关,按压开关一侧连接雾化器。本实用新型中,在雾化机构的作用下,避免了人工接触废酸溶液,对人体产生腐蚀,危害人们的健康,当废酸溶液被雾化喷洒时,则使得加热棒对其瞬间加热使其汽化。
中冶有色为您提供最新的江苏苏州有色金属固/危废处置技术理论与应用信息,涵盖发明专利、权利要求、说明书、技术领域、背景技术、实用新型内容及具体实施方式等有色技术内容。打造最具专业性的有色金属技术理论与应用平台!
 2025年10月23日 ~ 25日
2025年10月23日 ~ 25日  2025年10月31日 ~ 11月02日
2025年10月31日 ~ 11月02日  2025年11月07日 ~ 09日
2025年11月07日 ~ 09日  2025年11月14日 ~ 16日
2025年11月14日 ~ 16日  2025年11月14日 ~ 16日
2025年11月14日 ~ 16日 
